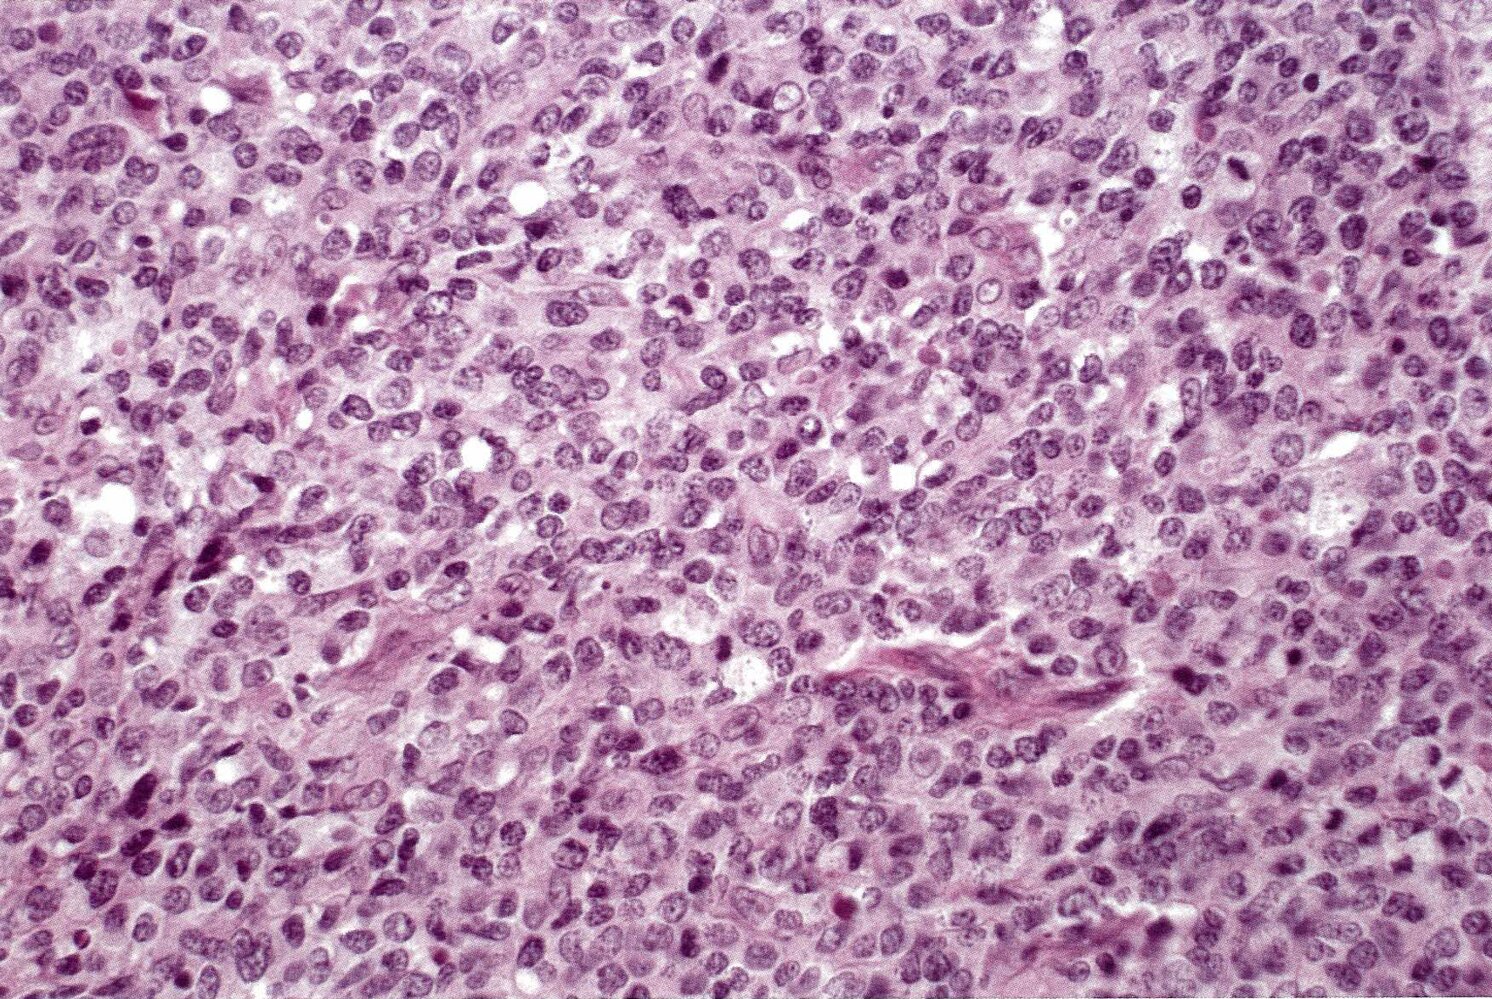

Hodgkin Lymphom Amboss, Hodgkin Lymphoma Knowledge Amboss
The two main kinds of lymphoma are Hodgkin lymphoma which spreads in an orderly manner from one group of lymph nodes to another. Basis-Infos für Patienten Angehörige.

Hodgkin Lymphoma Knowledge Amboss
Mögliche Ursachen sind unter anderem Lymphomatoide Granulomatose.

Hodgkin lymphom amboss. Bei Patienten im jungen Erwachsenenalter ist es jedoch eine der häufigsten Krebsdiagnosen. Location nodal or extranodal. Wie ist das Lymphsystem aufgebaut.
Die bösartige Krebsart die sich durch ein unkontrolliertes Zellwachstum auszeichnet entsteht in einem Lymphknoten des. Insgesamt zählt es zu den seltenen Krebserkrankungen. The incidence of HL has a bimodal age distribution with peaks in the 3 rd and 6 th 8 th decades of life.
Das mittlere Erkrankungsalter liegt zwischen 60 und 65 Jahren mit einer breiten Altersspanne. Das Hodgkin-Lymphom ist eine maligne Erkrankung des lymphatischen Systems. Symptoms typically include painless lymphadenopathy sometimes with fever night sweats unintentional weight loss pruritus splenomegaly and hepatomegaly.
Nicht alle Bereiche rund um die Lymphknoten zentriert. Verwenden Sie den Chatbot um Ihre Suche weiter zu verfeinern. Schauen Sie sich jetzt die ganze Liste der weiteren möglichen Ursachen und Krankheiten an.
Das Hodgkin-Lymphom auch Morbus Hodgkin genannt und Non-Hodgkin-Lymphome sind bösartige maligne Erkrankungen des lymphatischen Systems maligne Lymphome. Die genaue Ursache ist aktuell 2019 unklar. Rabu 13 Oktober 2021 Tambah Komentar.
Hodgkin-Lymphom - AMBOS. Das multiple Myelom MM. Diagnosis is based on lymph node biopsy.
Hodgkin lymphoma is a localized or disseminated malignant proliferation of cells of the lymphoreticular system primarily involving lymph node tissue spleen liver and bone marrow. Verwenden Sie den Chatbot um Ihre Suche weiter zu verfeinern. Beim MALT M ucosa A ssociated L ymphoid T issue-Lymphom handelt es sich um ein B-Zell-Non-Hodgkin-Lymphom mit meist niedrig-malignem Verlauf.
In den Tumorzellklonen nachgewiesen werden kann. Tuberculosis TB is a disease caused by Mycobacterium tuberculosis which typically affects the lungsIt is a common infectious cause of morbidity and mortality worldwide. Hodgkin Lymphoma Youtube.
Ätiologisch geht der Erkrankung oft eine Typ-B-Gastritis mit Helicobacter-pylori-Infektion voraus. Mehr Heilpraktiker Prüfungsfragen im DVD-Set Repetitorium Amtsarztprüfung. Lymphomas are malignancies that arise from lymphocytes and are classified as either Hodgkin lymphomas characterized by Reed-Sternberg cells or non-Hodgkin lymphomas NHLs which comprise all other types of lymphoma.
Zusätzliche Knotenlymphome befinden sich an Schleimhaut assoziiertem Lymphgewebe. Symptoms of Hodgkin lymphoma and non-Hodgkin lymphoma include swollen lymph. The WHO classifies HL into two types.
This lymphoma subtype accounts for 20 to 30 percent of all NHL cases. Frequent amplifications of the 9p241 locus in classical Hodgkin lymphoma could be the basis for the success of immune checkpoint inhibitors targeting PD-1 or PD-L1. Schauen Sie sich jetzt die ganze Liste der weiteren möglichen Ursachen und Krankheiten an.
Charakteristisch für das klassische Hodgkin-Lymphom das ca. Das follikuläre Lymphom ist das häufigste indolente Non-Hodgkin Lymphom NHL in Westeuropa und den USA in Asien ist es sehr selten. Das follikuläre Lymphom macht in unseren Breiten 2035 aller neu diagnostizierten NHL-Patienten aus.
Mögliche Ursachen sind unter anderem Non-Hodgkin-Lymphom. Httpgoogl28uFdVHeilpraktiker Prüfungsfragen im Blog. Non-Hodgkin-Lymphom ist eine heterogene Gruppe von Zuständen die keine Reed-Sternberg-Zellen aufweisen.
Mögliche Ursachen sind unter anderem Anämie. Hodgkin lymphoma HL is a malignant lymphoma that is typically of B-cell origin. Leukemia is used for neoplasms that present with widespread involvement of the bone marrow and the peripheral blood usually.
Die meisten sind B-Zell-Lymphome. Schauen Sie sich jetzt die ganze Liste der weiteren möglichen Ursachen und Krankheiten an. Variable Hodgkin lymphoma 100 Primary CNS lymphoma Focal neurological deficits neuropsychiatric symptoms signs of ICP andor seizures.
Other symptoms include fever night sweats feeling tired and weight loss. Das lymphatische System gehört zum Immunsystem des Körpers und schützt ihn vor Infektionen. Morbus Kahler ist ein B-Zell-Non-Hodgkin-Lymphom das durch eine monoklonale Plasmazellvermehrung im Knochenmark charakterisiert istDer Begriff multiples Myelom bezeichnet dabei eine diffuse Infiltration des Knochenmarks während Plasmozytom für eine solitäre Plasmazellvermehrung steht und streng genommen eine Sonderform.
Das Hodgkin-Lymphom ist eine maligne Erkrankung des lymphatischen Systems wobei sich die neoplastischen Zellen fast immer von B-Lymphozyten ableiten. Non-Hodgkin lymphoma which spreads through the lymphatic system in a non-orderly. Die neoplastischen Zellen lassen sich in der überwiegenden Zahl der Fälle von B-Lymphozyten ableiten.
Mögliche Ursachen sind unter anderem Systemischer Lupus erythematodes. Primary infection transmitted via airborne aerosol droplet nuclei is often initially asymptomatic. Eine Assoziation mit dem Epstein-Barr-Virus EBV wird vermutet da entsprechende DNA in rund 50 bei HIV-Patienten sogar in über 90 dF.
Mögliche Ursachen sind unter anderem Anämie. Verwenden Sie den Chatbot um Ihre Suche weiter zu verfeinern. Verwenden Sie den Chatbot um Ihre Suche weiter zu verfeinern.
95 aller Fälle ausmacht ist eine geringe Zahl von malignen Hodgkin-Reed-Sternberg H-RS Zellen die von zahlreichen reaktiven Zellen Bystander Cells umgeben. Das Hodgkin-Lymphom früher auch Morbus Hodgkin genannt ist eine bestimmte Art von Lymphknotenkrebs. Erythem Hodgkin-lymphom Raynaud-phaenomen.
EBV HIV und andere Ursachen der Immunkompromi- sierung haben eine erhöhte Inzidenz von Non-Hodgkin-Lymphomen. Classical HL CHL and nodular lymphocyte -predominant HL NLPHL. Es besteht aus Lymphgefäßen Lymphknoten und lymphatischen Organen wie den Mandeln und der Milz.
Hodgkin lymphom amboss deutsch. Schauen Sie sich jetzt die ganze Liste der weiteren möglichen Ursachen und Krankheiten an. Das Hodgkin Lymphom ist eine bösartige Krebsart des lymphatischen Systems einem wichtigen Teil der Immunabwehr des Körpers.
Schauen Sie sich jetzt die ganze Liste der weiteren möglichen Ursachen und Krankheiten an. Morbus Hodgkin ist ein B-Zell-Lymphom das häufig junge Erwachsene betrifftTypisch für die Erkrankung sind indolente Lymphknotenpakete die meist zervikal auftreten.

Lymphatic System Knowledge Amboss

Non Hodgkin Lymphomas Knowledge Amboss

Hodgkin Lymphoma Knowledge Amboss

Non Hodgkin Lymphomas Knowledge Amboss

Hodgkin Lymphoma Knowledge Amboss

Hodgkin Lymphoma Knowledge Amboss

Hodgkin Lymphoma Knowledge Amboss

Malt Lymphoma Knowledge Amboss
Non Hodgkin Lymphomas Knowledge Amboss

Non Hodgkin Lymphomas Knowledge Amboss

Non Hodgkin Lymphomas Knowledge Amboss

Diffuses Grosszelliges B Zell Lymphom Onkopedia

Hodgkin Lymphoma Knowledge Amboss

Hodgkin Lymphoma Knowledge Amboss

13 Hodgkin Ideen Lymphknoten Morbus Hodgkin Geschwollene Lymphknoten

Neoplasien Der Blutzellen Teil 2 Leukamien Lymphome Zuordnung Der Diagnosen Amboss Auditor Youtube


Post a Comment
Post a Comment